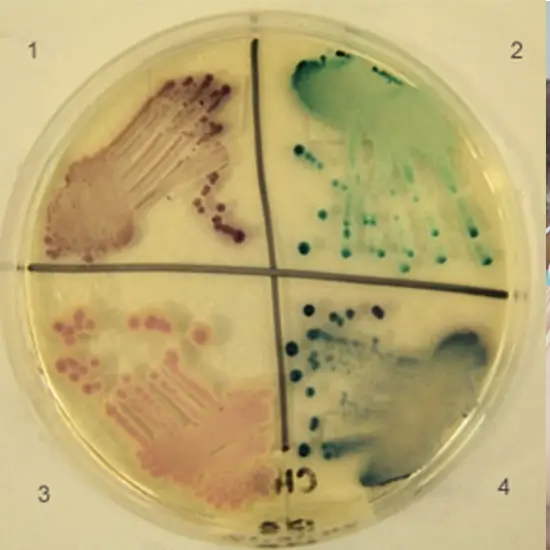

Book Rapid Fungal Culture and Sensitivity Appointment Online Near me at the best price in Delhi/NCR from Ganesh Diagnostic. NABL & NABH Accredited Diagnostic centre and Pathology lab in Delhi offering a wide range of Radiology & Pathology tests. Get Free Ambulance & Free Home Sample collection. 24X7 Hour Open. Call Now at 011-47-444-444 to Book your Rapid Fungal Culture and Sensitivity at 50% Discount.
A fungi culture test aids in diagnosing fungal infections (more than one fungus). Fungal germs live in the air, soil, plants, and even our bodies. Therefore, a rapid diagnostic test for fungal infections can be used to confirm the presence of a fungal infection. In addition, the test may aid in the identification of specific fungi, in guiding treatment, or in determining the efficacy of fungus treatment.
If you exhibit fungal infection-related symptoms, your doctor may order a fungal culture test. Symptoms vary depending on the infection type. Symptoms of superficial fungi include:
Severe systemic fungal infection symptoms include:
Procedure:
The lab technician will provide details.
No preparation is needed.
Required Documents for the Rapid Fungal C/S Test
After Care:
No care is required.
The Fungal Culture Test price in India cost varies by region and facility. So constantly get tested at trustworthy diagnostic centers like Ganesh Diagnostic. It is staffed by trained and experienced professionals to assure patient and visitor safety.
| Test Type | Rapid Fungal Culture and Sensitivity |
| Includes | Rapid Fungal C/S Test (Lab Test) |
| Preparation | |
| Reporting | |
| Test Price |
₹ 700
|

Early check ups are always better than delayed ones. Safety, precaution & care is depicted from the several health checkups. Here, we present simple & comprehensive health packages for any kind of testing to ensure the early prescribed treatment to safeguard your health.